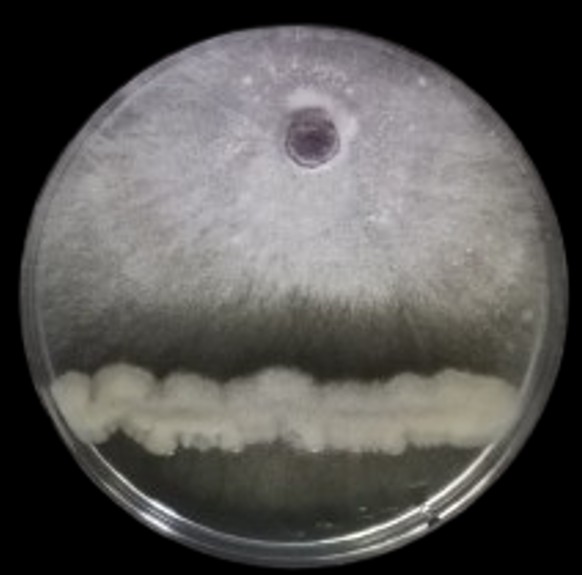

- 20-04-2026
Ανακήρυξη υποψηφίων για τη θέση του Διευθυντή στο Εργαστήριο Βελτίωσης Φυτών & Γεωργικού Πειραματισμού
Ο Διευθυντής του Τομέα Γεωργίας, Βελτίωσης Φυτών, Βιομετρίας & Μετεωρολογίας του ΤμήματοςΕπιστήμης Φυτικής Παραγωγής, […]More ... - 15-02-2023
Registration of foreigners 2022-2023
"Sanction of tables of those admitted to the Departments/Admission Directions and Schools of Higher […]More ... - 21-09-2022
Online registration of successful 2022 in higher education
We inform you that according to the announcement of the Ministry of Education and Religious AffairsMore ...
Recent Announcements
Search for announcement20
Mon
Ανακήρυξη υποψηφίων για τη θέση του Διευθυντή στο Εργαστήριο Βελτίωσης Φυτών & Γεωργικού Πειραματισμού
Ο Διευθυντής του Τομέα Γεωργίας, Βελτίωσης Φυτών, Βιομετρίας & Μετεωρολογίας του ΤμήματοςΕπιστήμης Φυτικής Παραγωγής, […]
Monday 20 April
15
Wed
Registration of foreigners 2022-2023
"Sanction of tables of those admitted to the Departments/Admission Directions and Schools of Higher […]
Wednesday 15 February
21
Wed
Online registration of successful 2022 in higher education
We inform you that according to the announcement of the Ministry of Education and Religious Affairs
Wednesday 21 September
Courses
All courses1st SEMESTER
2nd SEMESTER
3nd SEMESTER
4th SEMESTER
5th SEMESTER
6th SEMESTER
7th SEMESTER
8th SEMESTER
9th SEMESTER